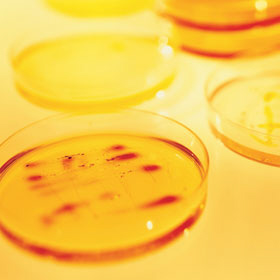

028 38 352640

Contact Us
Greenmount Veterinary Clinic
72 Gilford Road,
Portadown, Co Armagh,
BT63 5EG
Tel: 028
38 358525/352640

In- house laboratory
We are able to offer accurate, rapid diagnosis of many diseases within a few minutes as a result of our on -site laboratory .
A variety of idexx analysers allow us to carry out full blood testing in our on-site laboratory, including:
Red and White cell counts/ profiles (Haematology)
Anaemia & Infections
Biochemistry profiles
Kidney disease
Diabetes mellitus
Liver disease
Canine & feline Viral testing for Felv/ FIV & canine parvovirus
Also carried out are:
Urine analysis
Skin scrapings and Parasitology
Fine needle aspirates and cytological examination of smears



This service allows us to quickly assess your pets condition 24 hours a day, 365 days a year so we may begin the correct treatments immediately without having to wait for postage and external laboratories. Tests can be easily repeated to monitor your pets progress.

Website content owned and produced by Ewing Walker, Ewing may be contacted through Greenmount Veterinary Clinic or VetOrtho Referrals. Copyright © All rights reserved. Ewing Walker Greenmount Vets
| pet grooming |
| fleas & ticks |
| pet microchip |
| pet insurance |
| pet worming |
| pet neutering |
| vaccinations |
| dogs trust scheme |
| dog neuter for £15 |
| rabbits |
| cats |
| dogs |
| dental treatments |
| spinal xray myelogram |
| GSDA A stamp |
| elbow score |
| hip score |
| hip score guide for owners |
| our healthy pet offers |
| vetortho.co.uk |
| Fracture Surgery |
| Cruciate Surgery TTA TPLO |
| Hip Dysplasia |
| Spinal Surgery |
| Elbow Dysplasia |
| Cardiology services offered |
| Doppler heart scan |
| Blood pressure monitoring |
| Electrocardiogram ECG |
| Holter monitoring |
| Bronchoscopy & Endoscopy |
| ophthalmology referrals |
| cataract surgery |
| eye-vet |